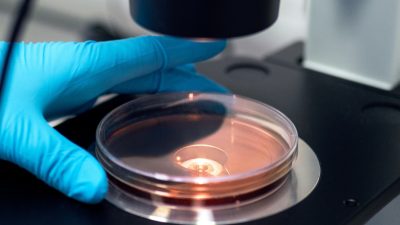

Gaining transferable skills studying BSc Biomedical Science
At Salford, our focus is on teaching our students the industry-standard skills and transferable skills they need to succeed in the world of work. We caught up with Wiktoria, a BSc Biomedical Science student, to find out she is developing these skills and what else she is enjoying about her time so far at Salford. […]